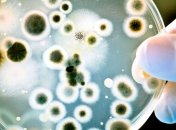
17 киевлян заболели сальмонеллезом

Новости по теме Сальмонеллез
-

Аномальная вспышка сальмонеллеза произошла в Украине
-

Врачи не советуют игнорировать первые проявления кишечной инфекции, ведь последствия могут быть роковыми
-

Мультирезистентные бактерии вызывают опасные заболевания крови и распространяют гены устойчивости к антибиотикам.
-

Число заболевших в результате вспышки кишечной инфекции в детсаду в Нетешине превысило 50.
-

В детском саду города Збараж Тернопольской области зафиксирована вспышка сальмонеллеза.
-

В Тернопольской области в г.Збараж выявлена вспышка инфекционного заболевания, причиной могли стать куриные яйца.
-

У четырех пострадавших в результате отравления суши диагностировали сальмонеллез.
-

В Ровенской области 11 человек госпитализированы с сальмонеллезом, сообщили в ГСЧС Украины.
-

В Киеве осудили заведующую, медсестру и повара детсада, по вине которых массово отравились дети.
-

У 12 госпитализированных подтвержден диагноз – сальмонеллез. Состояние госпитализированных - легкой тяжести.
-
В Киеве 17 человек заболели сальмонеллезом.




